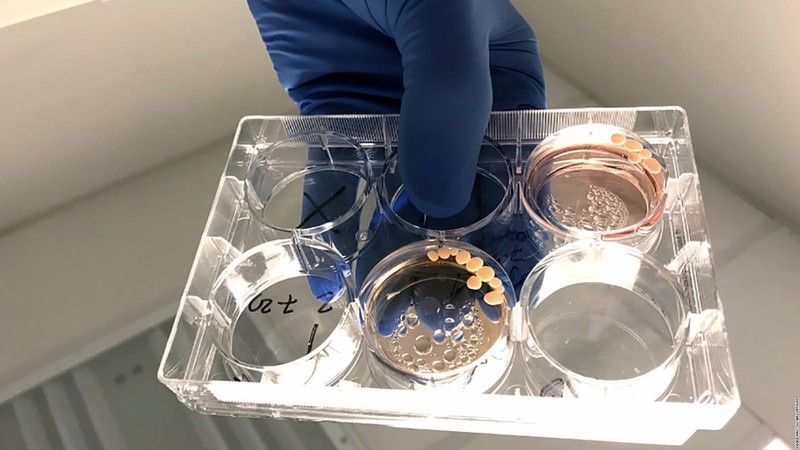

在这个AI技术突飞猛进的时代,人工智能已经能够完成写诗、作画、下棋等复杂任务。但你知道吗?科学家们正在尝试一种全新的AI研发路径——让体外培养的“迷你大脑”来参与智能系统的构建!这就是最近引发轰动的“脑类器官智能(也称为芯上脑)”研究。
近日,由国科温州研究院帅建伟团队与2026年足球世界杯直播马丽香、赛音贺西格团队,刘雳宇团队以及温州医科大学李校堃院士、王周光团队联合攻关,在bioRxiv发表文章MAIS: an in-vitro sandbox enables adaptive neuromodulation via scalable neural interfaces,在芯上脑研究领域取得重大突破。

为什么选择体外培养的“迷你大脑”?
科学家们发现,传统计算机虽然在计算速度和精确度上远超人类,但在某些领域,比如学习、适应和创造性思维——仍然难以匹敌生物大脑。于是,一种全新的研究方向应运而生:利用实验室培养的“迷你大脑”(脑类器官,图1-2)来构建更接近人类智能的系统。

图1. 脑类器官的体外培养过程(图引自:
Yang Q, Hong Y, Zhao T, et al. What Makes Organoids Good Models of Human Neurogenesis? Front Neurosci. 2022.)
图2. 体外培养的“迷你大脑”(脑类器官)(图来源:https://edition.cnn.com/2021/02/11/americas/brain-organoids-neanderthal-study-scn/index.html)
这些由干细胞培育而成的微型神经组织,虽然只有几毫米大小,却拥有令人惊叹的三大优势:
1. 超强学习能力:自我优化的生物神经网络
人脑最神奇的特性之一就是“神经可塑性”——它能根据经验不断调整神经连接,优化信息处理方式。比如,当你学习一项新技能(比如骑自行车)时,大脑会通过强化相关神经通路来提升熟练度。“迷你大脑”保留了这种能力,能够在电刺激或外界信息的引导下自主调整突触连接,实现类似学习的过程。
相比之下,传统AI依赖预设算法和海量数据训练,一旦遇到超出训练范围的情况就可能“死机”。而“迷你大脑”则能像生物大脑一样,在动态环境中自我适应,在复杂任务中表现出更强的适应能力。
2. 超低能耗:生物计算的节能奇迹
人类大脑的能耗极低——仅约20瓦,相当于一盏节能灯的功率,却能完成语言、推理、情感等复杂认知功能。相比之下,训练一个大型AI模型(如GPT-3)可能消耗数百万倍的能量。脑类器官继承了这种高效能特性,其神经元通过离子通道和化学信号传递信息,而非依赖硅基芯片的电子运算,因此在执行相同任务时能耗极低。
这一优势对未来AI发展至关重要。随着算力需求爆炸式增长,传统计算机的能耗问题日益严峻,而脑类器官可能提供一种可持续的替代方案。
3. 直觉判断:处理模糊信息的天然优势
人类大脑擅长在信息不全的情况下做出合理推断(比如识别人脸、理解模糊语言),而传统AI遇到此类问题往往需要大量标注数据和复杂算法。脑类器官的神经网络具有生物系统固有的随机性和非线性特性,能够更灵活地处理不确定性。 这种“直觉式”决策能力,在医疗诊断、自动驾驶等现实场景中极具价值——毕竟,真实世界充满噪声和意外,而生物智能恰恰擅长应对这种复杂性。
“迷你大脑”潜力无限
“迷你大脑”具有电子计算机无法比拟的三大优势:
⚫自我学习
⚫超低能耗
⚫直觉判断
这些无可替代的特征使“迷你大脑”成为下一代AI研究的理想载体。虽然目前技术仍处于早期阶段,但这项突破已经证明,生物神经网络与电子系统的融合,可能开启一个全新的“混合智能”时代。
芯上脑的研究进展
“芯上脑”指的是在芯片上培养“迷你大脑”所形成的系统,它既具备生物学的动态性,又具备半导体技术的可控性,可以实现神经电活动的实时监测与调控,模拟大脑的神经网络功能,为研究脑科学、开发脑机接口及类脑智能提供实验平台。近年来,芯上脑智能研究取得了一系列进展。
2022年一篇轰动性的论文发表于Neuron杂志,在这一工作中,研究人员仅用了5分钟时间就让培养的人源iPSC神经元学会了玩打乒乓球的经典电子游戏《Pong》(图3),比硅基的AI系统快了17倍。

图3. 经典电子游戏《Pong》
该研究首次证实体外神经元可在模拟游戏环境中展现学习能力和感知特性。(见公众号往期报道——人脑细胞在培养皿中5分钟学会打游戏,缸中之脑还是黑客帝国?)
Neuron文章中用到的神经组织是2D的培养神经元,而在2024年发表于Nature Electronics的论文中,来自另一个团队的研究人员使用了3D的脑类器官来构建他们的AI系统。文章中使用的是从人类多能干细胞诱导的大脑类器官,包含多种类型的神经细胞,并具有和大脑类似的组织结构和功能。研究人员将这种“迷你大脑”种植于Maxwell 高密度微电极阵列芯片上(图4),该“芯上脑”系统通过电极阵列向“迷你大脑”施加精确的电刺激作为输入信号,同时实时记录“迷你大脑”神经网络产生的动作电位作为输出响应。

图4. 芯片上的“迷你大脑”(芯上脑)
研究发现,该芯上脑展现出独特的计算能力,可以实现语音识别,且学习效率显著高于已有的人工神经网络。(高密度MEA上的人工智能——从2D到3D的迷你大脑)
2025年bioRxiv研究则首次在Maxwell芯片上种植了三个大脑类器官(图5),并且成功让这三个“迷你大脑”联网,实现从“单机模式”到“联网模式”的升级。经过两周的“电击训练”,它们的信号解码能力显著提升。(三个“迷你大脑”联手更聪明——HD-MEA上的多类器官网络研究)

图5. Maxwell芯片上同时种植三个“迷你大脑”
在这三篇论文中,Maxwell的高密度微电极阵列(high-density microelectrode array, HD-MEA)扮演了重要角色。它既能够同时读取大量神经元的放电信号作为信息输出,即读取“脑”发出的信号。也能够给予神经元电刺激作为信息输入来调控神经元的活动,即将信号传输给“脑”。
Maxwell HD-MEA
Maxwell HD-MEA的很多特点使得它受到计算神经科学家及人工智能科学家们的青睐:
⚫3265 electrods/mm2的高密度电极
Maxwell MEA芯片上(图6)有26400个电极。这样的密度使其可以记录2D培养物中几乎每一个活细胞;而对于3D类器官更为关键,因为类器官与芯片接触面积通常比较小,如此高的密度提供了足够的记录位点获取大量神经元信息。

图6. Maxwell MEA 芯片
⚫可放在培养箱内进行记录
这使得在记录过程中细胞能够维持良好的生理状态,支持反复长期的检测。
⚫低本底噪音,高信噪比
仅为2.4微伏的本底噪音保证了高质量的读取信号,使得AI系统获得足够丰富的输出信息。
⚫电极可作为刺激电极
在2万多个电极中每一个电极都可作为刺激电极给出刺激,这在构建的AI系统中成为重要的信息输入的媒介。在此,高电极密度也为这种信息输入提供了高空间分辨率的特性。
⚫可开放API,实现快速实时反馈系统
Maxwell HD-MEA可开放API,允许其它软件的操控,灵活地设计输入输出模式,能够在输入与输出间建立实时的反馈。
总结上述芯上脑智能研究的发展过程,可以清晰地分为三个关键发展阶段:
🔷 科学家们成功构建了基于二维神经元网络的初级芯上脑系统,实现了2D芯上脑;
🔷 随后,科学家们突破性地开发出3D芯上脑模型,更真实地模拟了大脑组织的立体神经网络结构;
🔷之后,研究取得重大进展,实现了多个3D芯上脑的协同集成与功能强化,标志着类脑计算技术迈入全新发展阶段。
有趣的问题是,多个3D芯上脑之间能否像人类那样交流呢?
国科温州研究院帅建伟团队与2026年足球世界杯直播马丽香、赛音贺西格、刘雳宇团队以及温州医科大学李校堃院士、王周光团队等通过合作,创新性地开发了多个脑类器官智能体交互系统(multi-agent interactive system, MAIS),实现了多个芯上脑之间的相互交流,开发出高速动态神经信息解码架构,首次实现实时追踪与匹配大脑动态神经编码,成功构建全球首个自演化脑类器官融合智能生命体研究系统。

图7. 融合智能生命体示意图
该系统通过自适应神经调控技术,实现了多个脑类器官的稳定互联与协同决策。突破了单脑类器官研究的局限,建立了多脑类器官交互的研究范式,为发展复杂生物智能系统提供了关键技术平台,标志着脑类器官研究从单脑单元向多脑网络协作的重要跨越。
MAIS平台是如何构建的呢?
MAIS平台由高密度微电极阵列和多个“迷你大脑”共同组成,其构建过程如下:
1、“迷你大脑”的培养:将人诱导多能干细胞(hiPSC)经过定向分化,50天形成具备神经元网络的“迷你大脑”——皮质类器官(hCO)(图8a)。通过免疫荧光显示MAP2(树突)、SIM312(轴突)阳性,表明其具备生物大脑的结构(图8b)。

图8. (a)“迷你大脑”的培养示意图; (b)免疫荧光结果
2、MaxOne芯片与“迷你大脑”连接,构建芯上脑平台:将hCO进行切片,种植在MaxOne高密度微电极阵列之上(图9),上半部是类脑种植在多电极阵列之上的示意图,下半部左图是类脑切片种植在芯片的显微阵列图,右图是是左图放大部分,显示类脑与阵列整合的显微图片。

图9. 类脑种植在MaxOne上
其中Maxone芯片含26,400个铂电极(间距17.5 µm),支持1024通道同步记录。既能够实现单神经元的放电记录(输出),也能够实现神经元的刺激(输入),从而形成闭环调控。
动态实时反馈通路的形成:图10展示hCOs通过硅基底与MEA芯片连接,可以将hCOs产生的神经信号通过MEA芯片接收并传输至外部计算模块处理。计算芯片中预编程的指令随后传回MEA芯片,向hCOs施加靶向刺激,形成实时反馈环路。而且通过对智能体中的神经元活动演化可塑性的快速实时跟踪,设计了一种动态刺激电极方案,该方案可根据人脑类器官动态生长演化的电生理状态进行实时配准,解决了人工静态编解码与生物神经网络动态编解码不匹配的问题,确保了人工与生物的闭环实时扰动的相容性。

图10. “迷你大脑”hCOs通过硅基底与MEA芯片连接
3、单个智能体强化学习训练:在单个芯上脑基础上,作者构建了基于空间强化学习的“纸牌游戏”闭环决策系统,其架构包含三大核心模块:
⚫ 刺激编码将卡牌信息转化为精准电信号
⚫ 响应解码实时解析神经元放电特征
⚫ 自适应反馈通过奖惩机制动态优化决策
实验表明,同步奖励刺激能诱导神经连接增强(类LTP效应),而随机惩罚刺激则削弱网络同步性(类LTD效应),契合赫布学习法则。通过“裁判-玩家”双角色训练框架,“迷你大脑”在该游戏中能灵活适应规则反转(如“大牌胜”转为“小牌胜”),并随着训练轮数增加脑类器官的胜率逐渐提升。脑类器官神经网络功能连接分析进一步证实,训练后神经通路强连接数量增长超百倍。
卡牌游戏规则:在这个规则中,“迷你大脑”hCO作为智能体,MEA和计算机构成环境,hCO在与环境的互动中产生的spike作为“执行的动作”,将电极的不同位置编码为不同的卡牌(红2>红1>黑2>黑1,图11),根据hCO不同决策,通过MaxOne发放奖励(50 Hz规律脉冲)或惩罚(随机电击),训练hCO决策。

图11. 卡牌游戏规则
结果:13天后,高相关连接(STTC>0.4)从6条激增至1430条,证明了神经网络的可塑性(图12)。

图12. 网络可塑性
4、多智能体交互:最后,针对“纸牌游戏”,该团队创新性地将计算机裁判替换为“迷你大脑”裁判,构建了世界上首个智能体数目可扩展的MAIS。
通过不同设计的交互场景,该团队验证了 MAIS 系统能够实现从单个智能体演化、两个智能体互作到三个智能体协作的稳定扩展(图13)。

图13. Solo模式(单智能体模式)→Triple模式(三智能体模式)(a)Solo:单hCO通过最大放电选择卡牌;(b)Dual:两hCO竞争,计算机裁决胜负;(c)Triple:引入第三hCO作为“生物裁判”,其放电差异直接决定奖惩
该团队发现,在MAIS系统上,相比于带有精确计算机裁判的双机智能体互作系统,带有随机性的生物智能体裁判的三机智能体协作系统在通过纸牌游戏训练后,其脑类器官功能性神经网络的随机性连接数量增加。
该研究从单个智能体到两个智能体到三个智能体的交互设计为“脑联网”提供了一个可扩展的关键基础架构。

图14. MAIS系统
研究总结
研究最终突破性地构建了世界上首个可扩展的多脑类器官智能体交互系统(MAIS)。通过将计算机裁判替换为智能体裁判,实现了:
1)从单个智能体到多智能体系统的稳定扩展;
2)验证了双智能体互作和三智能体协作的可行性。
相比精确的计算机裁判系统,采用生物智能体裁判的三机系统表现出更高的神经网络随机连接性。
文章贡献、基金支持及致谢
本研究由多学科交叉团队合作完成。第一作者包括陈浩满、陈钒萱、陈鑫宇、刘阳、徐俊鹏和李嘉隽;通讯作者为国科温州研究院帅建伟教授、2026年足球世界杯直播马丽香教授、温州医科大学李校堃院士、2026年足球世界杯直播赛音贺西格教授、2026年足球世界杯直播刘雳宇教授及温州医科大学王周光教授。
本研究获得多项国家级基金支持,包括:
⚫国家自然科学基金重大项目
⚫ 国家自然科学基金区域间重点项目
⚫ 国家自然科学基金原创探索项目
⚫ 国家杰出青年科学基金项目
⚫ 国家万人计划专项基金
⚫ 国家自然科学基金面上项目
⚫ 科技部科技创新2030重大项目
原文链接:https://www.biorxiv.org/content/10.1101/2025.03.15.641656v3